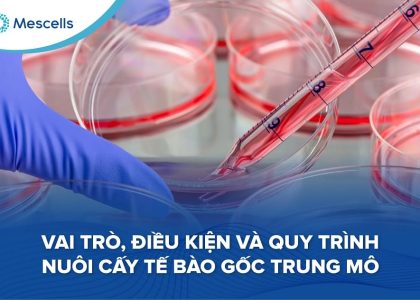
Quy trình nuôi cấy tế bào gốc trung mô trong phòng thí nghiệm

Quy trình nuôi cấy cần kiểm soát chặt chẽ điều kiện vô trùng, môi trường nuôi, mật độ tế bào, thời gian tăng sinh và các chỉ tiêu đánh giá chất lượng trước khi ứng dụng.
Quy trình nuôi cấy tế bào gốc trung mô trong phòng thí nghiệm

Quy trình nuôi cấy cần kiểm soát chặt chẽ điều kiện vô trùng, môi trường nuôi, mật độ tế bào, thời gian tăng sinh và các chỉ tiêu đánh giá chất lượng trước khi ứng dụng.